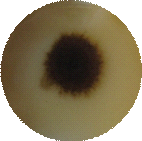

Экспертиза ассортимента и качества детского питания
Введение
питание
экспертиза детский гипермаркет
Актуальность данной работы в том,
что управление ассортиментом и оценка качества детского питания имеет огромное
значение для жизни и деятельности многих людей. Продавцу магазина, торгового
центра выгодно продать качественный продукт, чтобы не потерять покупателя. Для
людей, покупателей, имеет огромное значение качество приобретаемого товара.
В последние годы фальсификация на
российском рынке достигла невероятного размера. Причем подделки производятся
как на российском рынке, так и за рубежом. Это относится и к продуктам для
детского питания, в частности к плодово-ягодным консервам.
Проблема качества детского питания
особенно актуальна, поскольку здоровье детей - это основа здоровой нации. В
продукты для детского питания нельзя вносить консерванты и другие искусственные
добавки, чем в настоящее время пренебрегают некоторые производители, так как
большинство продукции выпускается по техническим условиям, требования которых
невозможно проследить.
Плодово-ягодные и овощные консервы
для детского питания подразделяются на соки и пюре. Важнейшими факторами,
формирующими качество продуктов детского питания, являются собственно сырье,
его химический состав и особенности технологии производства.
Плодово-ягодные консервы для
детского питания являются основными источниками витаминов и минеральных веществ
для детей. Однако в процессе технологии производства большая часть витаминов
разрушается, поэтому консервы детского питания проходится дополнительно
обогащать ими. В группу лечебно-профилактических консервов добавляют железо,
что усиливает их антианемический эффект.
Объектом данной работы, является
детское питание, продаваемое в ООО «Эссен».
Предметом данной работы является
характеристика управления ассортиментом и оценки качества детского питания в
ООО «Эссен».
Целью выпускной квалификационной
работы является выявление характеристик и оценки качества детского питания,
продаваемого в ООО «Эссен»
В связи с данной целью, поставлены
задачи:
рассмотреть пищевую ценность и
химический состав детского питания;
дать характеристику ассортимента
детского питания;
охарактеризовать требования,
предъявляемые к качеству детского питания;
выявить факторы, формирующие
качество детского питания;
выявить факторы, сохраняющие
качество детского питания;
произвести анализ и представить
результаты исследования;
рассмотреть упаковку и маркировку
исследуемых образцов;
применить органолептические методы и
привести результаты исследования;
применить физико-химические методы и
привести результаты исследования;
произвести анализ обеспеченности
торгового предприятия инвентарем и торгово-технологическим оборудованием
Эмпирической базой данного
исследования явился собственный анализ управлением ассортимента и оценки
качества товаров, проведенный в ходе прохождения преддипломной практики в
2013-2014 учебном году в ООО «Эссен».
Структура работы соответствует
логике поставленных целей и задач и состоит из введения, трех глав, заключения,
списка использованной литературы и приложений.
1. Аналитический обзор
литературы
.1 Пищевая ценность
и химический состав детского питания
питание экспертиза детский гипермаркет
Полезность пищевых продуктов зависит
от их химического состава и особенностей превращения отдельных пищевых веществ
в организме ребенка. В связи с этим различают: энергетическую, биологическую,
физиологическую, органолептическую ценность, а также биологическую
эффективность, усвояемость и безопасность продуктов детского питания. Пищевая
ценность характеризует всю полноту полезных свойств продукта и его вкусовые
достоинства, обусловленные содержащимися в нем разнообразными питательными
веществами. Пищевая ценность тем выше, чем в большей степени продукт
удовлетворяет физиологические потребности организма в этих веществах и
обеспечивает его нормальное функционирование. Энергетическая ценность
характеризуется суммарным количеством энергии, выделяемой при биологическом
окислении содержащихся в 100 г продуктов питательных веществах и используемой
для поддержания физиологических функций организма. В зависимости от
энергетической ценности все продукты детского питания можно условно разделить
на три группы.
Таблица 1. Классификация продуктов
детского питания по энергетической ценности (ЭЦ)
|
Группа продуктов и их ЭЦ, ккал/ 100 г Ассортиментная группа
|
Ассортиментная группа
|
|
Высококалорийные (350 - 500)
|
ПДП на молочной основе
|
|
Среднекалорийные (100 - 349)
|
ПДП на зерновой основе: мука и крупа (рисовая, гречневая,
овсяная, злаковая), макаронные изделия, растворимое печенье и др.
|
|
Низкокалорийные (25 - 99)
|
ПДП на фруктово-ягодной и овощной основе
|
Внесение крупяного компонента
увеличивает энергетическую ценность продукта, поскольку крупы богаты
углеводами. Согласно СанПиН 2.3.2.1078-01 биологическая ценность - это
показатель качества пищевого белка, отражающий степень соответствия его
аминокислотного состава потребностям организма в аминокислотах для синтеза
белка. По сравнению с обычной пищей продукты детского питания отличаются более
сбалансированным соотношением аминокислот, необходимых для обеспечения
пластического резерва детского организма, построения отдельных тканей и
органов, а также обеспечения роста. Поэтому продукты детского питания должны
быть биологически полноценными, так как им принадлежит важная роль в
обеспечении растущего организма основными компонентами пищи. Продукты детского
питания разных групп имеют различную биологическую ценность. Кроме того, в
СанПиН 2.3.2.1078-01 приведена формулировка биологически активных добавок к
пище, которые используют и при производстве продуктов детского питания. Таковыми
являются концентраты природных (идентичных природным) биологически активных
веществ, предназначенных для непосредственного приема с пищей или ведения в
состав пищевых продуктов. Такие добавки должны в максимальной степени
обеспечивать потребности ребенка. Биологическая эффективность - показатель
качества жировых компонентов, отражающих в продуктах содержание полинасыщенных
жирных кислот. К ним относится линолевая и линоленовая кислоты, которые
являются незаменимыми факторами питания, так как в организме человека они не
синтезируются, а поступают только с пищей. Физиологическая ценность -
способность компонентов продуктов детского питания активизировать деятельность
основных систем организма с помощью физиологически активных веществ, к которым
относятся следующие их группы: 1 - вещества, оказывающие возбуждающее действие
на нервную систему (алкалоиды; кофеин, теобромин, никотин, этиловый спирт); 2 -
вещества, влияющие на сердечно-сосудистую систему (минеральные вещества -
калий, магний, кальций; витамины - В1, РР); 3 - вещества, активизирующие
пищеварительную систему (минеральные вещества - натрий, хлор; ферменты,
фосфолипиды, витамины, клетчатка, гемицеллюлоза, пектиновые и ароматические
вещества, гликозиды, азотистые и безазотистые экстрактиновые вещества и др.; 4
- вещества, усиливающие иммунную систему, обладающие бактерицидными свойствами
(полифенолы, красящие и ароматические вещества, витамины - В1, РР, гликозиды,
органические кислоты); 5 - вещества, способствующие выведению из организма
экотоксинов: радионуклидов, солей тяжелых металлов и пр. (пектиновые вещества,
клетчатка, некоторые белки). Вышеуказанные вещества в ПДП должны находиться в
строго сбалансированном соотношении. С целью повышения физиологической ценности
в продуктах детского питания на зерновой основе (каши), вносят фруктово-ягодные
или плодоовощные добавки, а также орехи, мед, шоколад. Для улучшения вкуса в
некоторые виды каш добавляют безвредные ароматизаторы - ванилин, фруктовые
эссенции, о чем указывается на упаковке. Органолептическая ценность -
способность веществ продуктов детского питания воздействовать на органы чувств
ребенка и вызывать восприятие органолептических свойств: внешнего вида, цвета,
консистенции, вкуса и запаха, что тесно связано с усвояемостью продукта.
Усвояемость - выражается коэффициентом усвояемости, показывающим, какая часть
продукта в целом используется организмом, т.е. вовлекается в процессы обмена
веществ. Коэффициент усвояемости в продуктах детского питания зависит от
соотношения усвояемых, трудноусвояемых и неусвояемых веществ.
В состав продуктов детского питания
входят разнообразные вещества, которые по химической природе делятся на
неорганические и органические. К первым относятся вода и минеральные вещества,
а ко вторым - углеводы, белки, жиры, витамины, органические кислоты, дубильные,
красящие, ароматические вещества и др. Такие вещества, как углеводы, белки,
жиры, обладают энергетическими свойствами, а такие, как органические кислоты,
дубильные, красящие и ароматические вещества, придают продуктам детского
питания определенный вкус, аромат и окраску и, воздействуя на органы
пищеварения, играют важную роль в пищеварительных процессах.
Все продукты детского питания на
растительной и животной основе состоят в основном из одних и тех же веществ, но
в разных количественных соотношениях.
Вода в продуктах детского питания
находится как в связанном (сухие молочные смеси, крупы, мука для детского
питания и др.), так и в свободном состоянии (соки, пюреобразные продукты,
молоко для детского питания и т.д.).
По содержанию воды продуктов
детского питания можно разделить на две группы:
.продукты с низким содержанием воды
- от 4,0 до 15,0% (смеси сухие молочные ацидофильные с растительными
наполнителями, каши сухие молочные с теми же наполнителями, мука для детского
питания, макаронные изделия и т.д.);
.продукты с высоким содержанием воды
- от 60,0 и почти до 90,0%, в том числе в продуктах на мясной основе - от 62,8
(фрикадельки детские) до 79,0% (пюре мясное детское); на фруктово-ягодной и
овощной основе - от 60,0 (паста яблочная с сахаром) до 98,9% (сок томатный), в
продуктах на молочной основе - от 75,0 (творог детский) до 89,0% (кефир
детский).
Сухие вещества продуктов детского
питания представлены в основном углеводами, органическими кислотами, белками,
жирами, витаминами, минеральными и другими веществами.
Углеводы в организме выполняют
энергетическую функцию, обеспечивают нормальную функцию кишечника (клетчатка,
полуклетчатка), защищают слизистую оболочку кишок от механических и химических
раздражителей (пектиновые вещества). Поступают в детский организм только с
продуктами, изготовленными с добавлением растительного и крупяного компонента.
Общее соотношение белков, жиров и углеводов в рационе должно быть 1: 1: 4,5.
Наиболее богаты углеводами продукты детского питания на зерновой,
фруктово-ягодной, овощной и молочной основе, в продуктах на мясной и рыбной
основе их количество ничтожно мало (табл.2).
Таблица 2. Содержание углеводов в
продуктах детского питания разных подгрупп (г/100г)
|
Подгруппа ПДП на основе
|
Сухие вещества
|
Углеводы
|
|
|
Моно- И дисахариды
|
крахмал
|
Клетчатка
|
|
Зерновой Мука для детского питания: гречневая рисовая
овсяная
|
|
1,6 0,4
|
72,1 81,6 67,6
|
1,0 0,4 1,8
|
|
Фруктово-ягодной и овощной Соки: морковно-виноградный;
абрикосовый с мякотью; сливово-абрикосовый с мякотью и сахаром;
сливово-вишневый с мякотью и сахаром; Пюре: кабачки с молоком томаты
протертые морковное яблочно-морковное
|
12,5 9,1 15,6 14,0 16,5 5,0 10.4 14,5
|
10,3 6,9 12,7 12,5 4,7 2,9 5,2 10,9
|
3,7 0,2 0,3
|
0,4 0,2 0,3 0,2 0,1 0,2 1,0 0,6
|
|
Молочной Сухие молочные смеси: Бифидолакт Детолакт
Малютка Молоко Ладушка сухое Жидкие продукты: Молоко Виталакт
обогащенное Кефир детский
|
14,1 11,0
|
45,3 52,5 49,6 53,0 7,3 4,1
|
4,1 1,5 0,2
|
|
Данные табл.2 показывают, что в
продуктах на зерновой основе источником углеводов, в частности крахмала и
дисахаридов, являются крупы и приготовленная из них мука, обеспечивающие
растущий организм энергией. Полисахариды представлены крахмалом, который хорошо
усваивается детским организмом. Высоким содержанием крахмала отличаются рисовая
и гречневая мука, 72,1 и 81,6% соответственно. По сравнению с этими видами
овсяная мука содержит несколько меньше крахмала - 67,6%. В продуктах детского
питания присутствуют небольшие количества дисахаридов (0,4-1,6%), которые придают
продукту слегка сладковатый вкус.
Для детского питания основными
поставщиками углеводов (крахмала, сахаров, клетчатки, гемицеллюлоз) является
продукты детского питания на зерновой основе.
Продукты на фруктово-ягодной и
овощной основе - фруктовые и овощные соки и пюре - также обеспечивают организм
ребенка углеводами, и прежде всего сахарами - глюкозой, фруктозой, сахарозой, в
меньшей степени - крахмалом, клетчаткой, пектиновыми веществами. Соки для
детского питания изготавливают чаще всего без добавления сахара, поскольку
моносахара и сахароза в достаточном количестве содержатся в плодоовощном сырье.
Однако в рецептуру соков для детей более старшего возраста добавляют сахар.
Особенно богаты сахарами виноградный, персиковый, абрикосовый соки, в 200 мл (т.е.
в одном стакане) которых содержится 25-35 г сахаров.
Продукты на фруктово-ягодной и
овощной основе отличаются большим содержанием моно - и дисахаров: в соках - от
6,9 (абрикосовый с мякотью) до 12,7% (сливово-абрикосовый); в пюре - от 2,9
(томаты протертые) до 10,9% (яблочно-морковное). Кроме того, в овощных пюре
присутствует немного крахмала - от 0,2 (морковное) до 3,7% (кабачки с молоком),
а также клетчатки - от 0,1 до 0,4% как во фруктовых, так и в овощных продуктах.
Сухие молочные продукты отличаются
повышенным количеством моно - и дисахаридов, в основном лактозы и сахарозы, -
от 45,3 (Бифидолакт) до 53,0% (Ладушка), тогда как в жидких продуктах их
содержание невелико - от 4,1 (Кефир детский) - до 7,3% (Виталакт). В молочные
смеси иногда для придания готовому продукту гетерогенной структуры в небольших
количествах добавляют крахмал. Так, в Виталакте его содержание составляет 0,2%,
а в Бифидолакте - 4,1%.
Содержание углеводов в продуктах
детского питания на мясной и рыбной основе, как уже отмечалось, невелико. Так,
в консервах Малыш, Пюре мясное детское и Язычок крупноизмельченный оно
составляет в среднем от 2,8 до 3,0% в зависимости от вида продукта.
Гемицеллюлоза (полуклетчатка) входит
в состав оболочек растительных клеток. К ним относятся гексозаны (галактан,
маннан) и пентозаны (арабан, ксилан). Содержание гемицеллюлоз в плодах в
среднем 0,1-0,7%.
Пектиновые вещества. К ним относятся
пектовые кислоты, пектин и протопектин, которые в основном состоят из остатков
лолигалактуроновой кислоты. Пектиновые вещества входят в состав клеточных
стенок и срединных пластинок, в цитоплазму и сок вакуолей растительных клеток.
Содержание их в плодах и овощах составляет в среднем 0,3-2,0%. Больше всего
пектиновых веществ в яблоках, айве, крыжовнике, черной смородине, облепихе. Они
играют важную роль в профилактическом и лечебном питании. Благодаря наличию в
молекуле карбоксильных групп пектин связывает тяжелые металлы и радионуклиды в
нерастворимые комплексы и выводит их из организма, т.е. обладают выраженными
радиопротекторными свойствами.
Продукты детского питания на
зерновой основе богаты растительными белками, которые перевариваются в
пищеварительном тракте детей хуже, чем животные белки. Повышенным содержанием
белков обладает овсяная и гречневая мука - соответственно 13,0 и 13,6%.
[9,с.130]
Поэтому Институтом питания РАМН
рекомендовано оптимальное соотношение белкового и жирового компонентов в мясных
продуктах, предназначенных для питания здоровых детей, которое должно
составлять 1:
. Высокое содержание полиненасыщенных
жирных кислот в этих продуктах обеспечивается в основном линолевой кислотой.
Данные по содержанию белков и жиров
в продуктах детского питания представлены в табл.3
Таблица 3. Содержание белков и жиров
в продуктах детского питания разных подгрупп (г/100г)
|
Подгруппа ПДП на основе
|
Белки
|
Жиры
|
|
Зерновой Мука: гречневая рисовая овсяная
|
13,6 7,4 13,0
|
1,2 0,6 6,8
|
|
Молочной: Сухие молочные смеси: Бифидолакт Детолакт Малютка
Молоко Ладушка сухое Жидкие продукты: Молоко Виталакт обогащенное Кефир
детский
|
17,5 13,7 15,0 13,1 2,3 2,9
|
24,0 27,0 25,0 26,0 3,6 3,2
|
|
Мясной: Малыш пюреобразное Пюре мясное детское Язычок
крупноизмельченный Куриное рагу с рисом ("Бона", Финляндия) Курочка
с овощами ("Хайнц", Италия) Телятина с овощами ("Хайнц",
Италия) Мясо индейки с пюре из овощей ("Нестле", Германия)
|
13,4 11,0 8,9 3,5 2,1 2,1 3,1
|
6,3 6,4 10,1 3,5 2,0 2,0 3,0
|
|
Рыбной: Золотая рыбка (из судака) Геркулес (из судака)
Конек-горбунок (из судака)
|
5,2 5,0 5,1
|
11,2 9,1 8,6
|
По табл.3 видно, что по сравнению с
жидкими сухие молочные смеси отличаются повышенным содержанием белков, что
обусловлено способами их изготовления и рецептурой. Так, в жидких продуктах
белка содержится от 2,3 (молоко Виталакт) до 2,9% (Кефир детский), а в сухих -
от 13,7 (Детолакт) до 17,5% (Би-фидолакт).
Сравнивая состав мясных и
мясорастительных консервов, можно сказать, что первые отличаются повышенным
содержанием белков - от 8,9 (Язычок) до 15,7% (паштет Богатырь), жиров - от 5,9
(Малыш гомогенизированный) до 15,4% (паштет Богатырь). В мясорастительных же
консервах содержание белков было несколько меньшим и составило: белков - от 2,1
до 3,5%, жиров - от 2,3 до 3,5%.
1.2 Товароведная
характеристика детского питания
Группа продуктов детского питания
подразделяется на подгруппы в зависимости от основного сырья.
Наряду с вышеизложенной товароведной
классификацией для сравнения приведем классификацию, применяемую в медицинской
практике, где выделяют четыре группы продуктов, необходимых ребенку' на весь
период роста и развития (в мл):
группа - белоксодержащие продукты
(мясо, рыба, яйцо, творог, сыр, горох, фасоль, соя, чечевица);
группа - молоко и молочные продукты.
Суточная потребность в них составляет 500-600 г независимо от возраста;
группа - жиры, которые должны
включать животное масло, растительное масло, рыбий жир натуральный
невитаминизированный тресковый;
группа - фрукты и овощи (кроме
картофеля), в том числе соки.
Предлагаемая медицинская
классификация позволяет рассчитать суточную потребность в вышеуказанных
продуктах в домашних условиях с учетом возраста ребенка.
Продукты на зерновой основе вводятся
в рацион питания детей первого года жизни с 6 мес. как основной источник
углеводов - крахмала, клетчатки, гемицеллюлозы и т.д. Их товароведная
классификация осуществляется по виду сырья, из которого они изготовлены, и
способу технологической обработки (рис. 2).
В отличие от продуктов, требующих
варки, быстрорастворимые (инстантные) мука и каши обогащены витаминами,
минеральными солями, сухими плодоовощными добавками, в них также добавляются
соответствующие ароматизаторы.
Продукты на зерновой основе вводят в
рацион ребенка с учетом их белкового, углеводного, витаминного и минерального
состава. В международной практике распространенные злаковые продукты прикорма
обогащаются кальцием, железом и основными витаминами. Количество каждого
витамина и минерального вещества составляет, как правило, не менее 25 и не
более 50% суточной потребности организма ребенка в них.
Каши по способу приготовления
условно можно подразделить на две группы - молочные и безмолочные. Для
восстановления первых требуется вода, вторых - специальное молоко для детского
питания, которое получают в цехах детского питания или на молочных кухнях.
Молочные каши после восстановления водой готовы к употреблению, в них ничего не
нужно добавлять.
В зависимости от возраста детей каши
промышленного производства дополнительно обогащаются комплексом витаминов и
минеральных солей, особенно кальция и железа, что составляет не менее 20 и не
более 50% суточной потребности.
Продукты детского питания на
фруктово-ягодной и овощной основе представлены консервами. Их производят из
высококачественных свежих плодов и овощей. Готовые продукты отличаются
прекрасными вкусовыми свойствами, наиболее благоприятным сочетанием белков,
жиров и углеводов (1:1:2 до 4), а также высоким содержанием витаминов, железа,
фосфора и других минеральных веществ. Консервы на фруктово-ягодной и овощной
основе представляют собой гомогенизированную пюреобразную массу. При их
изготовлении помимо растительного сырья добавляют поваренную соль, сахар,
сливочное масло, молоко, рис, муку и т.д.
Ассортимент отечественных консервов
для детского питания определен ГОСТ Р 52475-2005 (Консервы на фруктовой основе
для питания детей раннего возраста), где приведена их классификация по видам
плодовых и ягодных консервов. К ним относятся:
• пюре плодовые натуральные; из
смеси плодов натуральные; плодовые и ягодные с сахаром; из смеси плодов и ягод
с сахаром; из смеси плодов, ягод, овощей, плодовых я ягодных соков с сахаром;
из плодов с крупами и молоком; из плодов со сливками - Неженка;
• кремы плодово-ягодные;
• десерты плодово-ягодные;
•соки плодовые натуральные;
натуральные с сахаром; купажированные натуральные; плодовые и ягодные
купажированные с сахаром; с мякотью натуральные; с мякотью и с сахаром;
плодовые и ягодные купажированные с сахаром и с мякотью;
• компоты плодовые;
• консервы с добавлением витаминов.
Соки для детского питания готовят из
отборного сырья - натуральных плодов и ягод: слив, вишни, черешни, яблок,
абрикосов, персиков и др. Причем вид сырья определяет вид консервов.
Для детского питания выпускают соки
как осветленные, так и с мякотью, что обусловливает поступление в организм
детей пищевых волокон, стимулирующих деятельность желудочно-кишечного тракта.
По этой причине соки с мякотью вводят в рацион питания более старших детей, у
которых сформировалась более устойчивая слизистая оболочка кишечника. В этой
связи Институтом питания РАМН рекомендовано включать соки в рацион детей,
находящихся на грудном вскармливании, но не ранее 4-го месяца жизни.
Значение соков в детском питании
очень велико. Прежде всего соки - источник витаминов и многих других
биологически активных веществ. Кроме того, использование соков при лечении
острых инфекционных заболеваний и токсических состояний дает хорошие
результаты. При этом соки улучшают аппетит, утоляют жажду, способствуют
снижению энергетических потребностей, которые частично компенсируются за счет
потребления легкоусвояемых моносахаров, способствуют восстановлению водного и
кислотно-щелочного баланса и усилению мочевыделительной функции почек.
Последнее приводит к освобождению организма от инфекционных и токсичных
агентов, и промежуточных продуктов жизнедеятельности.
Фруктовое или фруктово-овощное пюре
вводится в рацион ребенка только после того, как в течение 2-3 недель он
принимал соки. Пюре имеет полужидкую консистенцию, для придания которой в
качестве структурообразователей (загустителей). Используют небольшие количества
крахмала, пшеничной муки (рисовой, манной и т.д.), пектины, гуаровую камедь и
др. Пюре выпускают гомогенизированными, мелкоизмельченными и
крупноизмельченными.[7,с.34]
Первоначально в рацион ребенка
вводят однокомпонентное пюре, т.е. из одного вида плодов (яблочное, грушевое,
персиковое, сливовое), а затем многокомпонентные.
Таким образом, с учетом возраста
ребенка в рацион питания вводят различные продукты, обладающие высокой пищевой
ценностью, что способствует обеспечению детского организма необходимыми для
роста и развития питательными веществами, а также постепенному переводу его на
обычную (твердую) пищу.
Продукты детского питания на
молочной основе предназначены для питания здоровых и больных детей различных
возрастных групп. Ассортимент этих продуктов согласован с органами
здравоохранения с учетом физиологических потребностей детского организма в
питательных веществах. Их применяют для искусственного вскармливания детей
первого года жизни в случае частичного или полного отсутствия материнского
молока.
Классификация продуктов детского
питания на молочной основе представлена в приложении 1.
В предлагаемой товароведной
классификации систематизированы такие наиболее существенные классификационные
признаки, как назначение продуктов детского питания, их консистенция и возраст
детей, а также наименее существенные - вид тары и способ термической обработки.
По назначению продукты детского
питания делятся на продукты для здоровых, недоношенных детей с малым весом и
больных, а по консистенции - на жидкие и пастообразные продукты, которые
изготавливаются из цельного коровьего молока и используются в питании ребенка
первого года жизни (в качестве прикорма), а также детей от 1 года до 3 лет. К
жидким и пастообразным молочным продуктам относят: молоко стерилизованное
(витаминизированное, Милковит и др.), кисломолочные продукты (Кефир детский),
творог (Творог детский, творог сублимированный и др.); молоко сухое, сухие и
жидкие молочные напитки, а также импортные консервы на молочно-фруктовой
основе: Йогурт с грушами («Хайнц», Италия); консервы Пюре из йогурта с грушами
(«Бона», Финляндия).
Мясо следует вводить в рацион
питания в измельченном, а консервы - лучше в гомогенизированном виде, поскольку
слизистая оболочка желудка и кишечника у детей нежная, ранимая. Поэтому
консистенция этих продуктов должна быть механически щадящей пищеварительную систему
детского организма. В то же время такие консервы должны обеспечивать
гарантированное по химическому составу, пищевой ценности и безопасности питание
малышей. Их применение снижает затраты времени и значительно облегчает процесс
приготовления пищи.[12;56]
В последние годы ассортимент мясных
консервов существенно расширился, причем он включает продукты как
отечественного, так и импортного производства. Эти консервы имеют различный
компонентный состав, консистенцию, степень измельчения, усвояемость и т.д. Выше
уже отмечалось, что выпускают как чисто мясные, так и мясорастительные
консервы. Чисто мясные консервы получают из натурального мясного сырья
(говядины, свинины, мяса птицы), подвергнутого тщательной обработке, к которому
может быть добавлен бульон, масло сливочное, масло растительное,
структурообразователи (крахмал, мука), лук.
Для улучшения потребительских
свойств консервов и придания приятного аромата в них добавляют гвоздику,
экстракты сельдерея и базилика, чабрец, укроп, петрушку, сельдерей, небольшое
количество поваренной соли, корригирующей вкус.
Многие виды мясных и
мясорастительных консервов обогащают железом, что является важным фактором,
предупреждающим железодефицитные состояния (анемии) у детей первого года жизни.
К продуктам прикорма на мясной
основе общего назначения относят консервы из мяса говядины, свинины, конины и
субпродуктов; консервированные колбаски; консервы из мяса птицы;
мясорастительные консервы.
Важнейшими классификационными
признаками являются вид и состав сырья.
В зависимости от консистенции и
возраста детей, для которых они предназначены, мясные консервы делят на
тонкоизмельченные (гомогенизированные); пюреобразные и крупноизмельченные.
Рыба наряду с мясом убойных животных
является высокобелковым продуктом (10-18%). Кроме того, она содержит жир
(0,8-20%), витамины группы В (В1, В2) и РР, минеральные вещества - фосфор,
калий, натрий, кальций, магний, а также йод, медь, бром, цинк, марганец,
кобальт и др.
Отечественная и зарубежная рыбная
промышленность выпускает рыборастительные консервы, в которых растительные
компоненты (овощи, крупы и пр.) присутствуют в объеме 10-20%. В качестве
рыбного сырья используют океанические (треску, минтай, лосось) и речные (судак,
карп) породы рыб. Эти консервы максимально готовы к употреблению: их необходимо
только разогреть. Рыборастительные консервы имеют повышенную пищевую ценность
за счет внесения других продуктов - растительного сырья, масла и т.д.
Рыбные консервы для детского питания
представляют собой измельченную однородную массу (кроме консервов дня
школьников), основу которой составляет мясо рыб (до 50%) с добавлением круп,
овощей, сухого молока, растительного и сливочного масла, репчатого лука, муки и
других компонентов, а также небольшого количества соли.
Консервы на рыбной основе производят
однокомпонентными (из одного вида рыбы), многокомпонентными (из разных видов
рыбы) и комбинированными (из рыбного, зернового и овощного сырья). В
многокомпонентные консервы на рыборастительной основе добавляют крупы, овощи,
репчатый лук. фасоль. бобы и др. В зависимости от консистенции и возраста детей
консервы бывают различной степени измельчения: гомогенизированные; пюреобразные;
крупноизмельченные и т.д.
1.3 Требования,
предъявляемые к качеству детского питания
Продукты детского
питания - пищевые продукты, предназначенные для питания детей в возрасте до 14
лет и отвечающие соответствующим физиологическим потребностям детского
организма, обеспечивающие эффективную усвояемость и не причиняющие вред
здоровью ребенка.
Продукты детского
питания и их компоненты, продукты для беременных и кормящих женщин должны
соответствовать гигиеническим нормативам безопасности и пищевой ценности (п.
3.34 СанПиН 2.3.2.1078-01 "Гигиенические требования безопасности и пищевой
ценности пищевых продуктов"). Гигиенические нормативы безопасности и
пищевой ценности продуктов детского питания указаны в Приложении 3 к СанПиН
2.3.2.1078-01 "Гигиенические требования безопасности и пищевой ценности
пищевых продуктов" [5,с.42]
В соответствии с п.
3.37 СанПиН 2.3.2.1078-01 "Гигиенические требования безопасности и пищевой
ценности пищевых продуктов" не допускается использование мяса птицы, кроме
охлажденного, мяса птицы механической обвалки и коллагенсодержащего сырья из
мяса птицы для производства продуктов детского (для всех возрастных групп, в
том числе для организованных детских коллективов), диетического (лечебного и
профилактического) питания, специализированных пищевых продуктов для питания
беременных и кормящих женщин.
Пищевая ценность
продуктов детского питания должна соответствовать функциональному состоянию
организма ребенка с учетом его возраста. Продукты детского питания должны быть
безопасными для здоровья ребенка (п. 3.33 СанПиН 2.3.2.1078-01
"Гигиенические требования безопасности и пищевой ценности пищевых продуктов"
и п. 2 ст. 15 Федерального закона от 02.01.2000 № 29-ФЗ "О качестве и
безопасности пищевых продуктов") [8,с.67]
По
органолептическим показателям консервы овощные, овоще-плодовые, овоще-мясные
для детского питания должны соответствовать следующим требованиям.
Внешний вид и
консистенция для овощных, овоще-плодовых пюре, овощных пюре с добавлением
других компонентов, овоще-мясные пюре гомогенизированных - однородная
тонкоизмельченная пюреобразная масса, протертых - однородная пюреобразная
масса.
При выкладывании
пюре на ровную поверхность образуется холмистая или растекающаяся масса.
Допускается при
хранении консервов отслаивание жидкости и жира.
Для овощных и
овоще-плодовых соков - однородная, непрозрачная жидкая масса с равномерно
распределенной гомогенизированной мякотью.
Допускается при
хранении консервов отслаивание жидкости.
Для всех видов
консервов допускаются единичные точечные вкрапления темного цвета, при хранении
- выпадение осадка светлого цвета.
Вкус и запах
натуральные, хорошо выраженные, свойственные данному виду продукции. Не
допускаются посторонние запах и привкус. Для консервов из моркови и печени
допускается естественная горечь.
Цвет однородный по
всей массе, свойственный консервированным овощам или смеси овощей, плодов и
ягод. [11,с.320]
Для консервов с добавлением молочных
продуктов - более светлый.
Сенсорная оценка, проводимая с
помощью органов чувств человека, - наиболее древний и широко распространенный
способ определения качества пищевых продуктов. Органолептические методы быстро,
объективно и надежно дают общую оценку качества продуктов
Таблица 4. Характеристика
органолептических показателей плодоовощных продуктов для детского питания
|
Наименование показателя
|
Характеристика
|
|
Внешний вид
|
Гомогенизированных консервов - однородная пюреобразная тонко
измельченная масса. Протертых консервов - однородная пюреобразная протертая
масса. Допускаются единичные вкрапления кожицы темного цвета.
|
|
Консистенция
|
При выкладывании пюре на ровную поверхность должна
образовываться холмистая или слегка растекающаяся масса.
|
|
Вкус и запах
|
Натуральные, хорошо выраженные, свойственные соответствующим
фруктам, или смеси использованных компонентов, прошедших тепловую обработку.
Не допускаются посторонние вкус и запах.
|
|
Цвет
|
Однородный по всей массе, свойственный цвету соответствующих
фруктов или смеси использованных компонентов. Допускается незначительное
потемнение поверхностного слоя или боковой поверхности содержимого банок
|
Для органолептической оценки
качества консервов для детского питания будет использована 5-балловая шкала с
использованием коэффициента весомости.
Распределим коэффициент весомости
для единичных показателей качества продуктов детского питания.
Таблица 5. Распределение
коэффициента весомости для единичных показателей качества продуктов детского питания
|
Показатель
|
Вкус
|
Запах
|
Консистенция
|
Внешний вид
|
Цвет
|
∑
|
|
Коэффициент весомости
|
5
|
5
|
5
|
3
|
2
|
20
|
Коэффициенты весомости варьируются в
зависимости от цели исследования и устанавливаются экспертным путем с
использованием метода ранжирования. Суть этого метода состоит в том, что
показатели располагают в порядке уменьшения их важности.
1.4 Факторы, формирующие
качество детского питания
Формирование
качества консервов для детского питания складывается на всех этапах
технологического процесса.
Консервы пюреобразные
включают подготовку сырья, разваривание и протирание, гомогенизацию, деаэрацию,
фасовку, укупорку и стерилизацию.
Подготовка сырья
Плоды и овощи
сортируют, моют, инспектируют и ополаскивают под душем. Эти операции проводятся
так же, как при выработке других видов консервов, но отличаются тщательностью
их проведения.
Картофель очищают
от кожицы и режут кружками или кубиками. Корнеплоды и лук чистят и нарезают.
Для первых обеденных блюд морковь предварительно бланшируют паром. При
консервировании в сметанном соусе нарезанную морковь тушат в расплавленном
коровьем масле, добавляя сахарный сироп.
Кабачки освобождают
от плодоножек и кожицы и разрезают. Тыкву очищают от семян и внутренней пленки
и режут на куски. У цветной капусты удаляют цветоножки и покровные листья, у
зеленого горошка - створки. Свеклу проваривают 25-50 мин при 120°С, очищают от
кожицы и измельчают на волчке.
Мясные туши
подвергают туалету. Затем мясо обваливают, жилуют, разрезают на куски массой
50-100 г и измельчают на волчке.
Печень жилуют,
вымачивают 2 ч в холодной проточной воде, режут на куски по 150-200 г и
бланшируют тушки.
Кур опаливают,
потрошат, моют, отделяют крылышки, лапки, головки и шейки, а затем разделанные
тушки кур варят 30-60 мин. После этого отделяют филе, которое измельчают на
волчке, получая фарш. К фаршу добавляют разваренные овощи и смесь протирают.
Сахар, соль, муку,
рис пропускают через магнит. Рис очищают, инспектируют, моют и разваривают.
Муку просеивают и просушивают. Сахар и соль растворяют в кипящей воде, растворы
фильтруют. Молоко фильтруют и нагревают. Сливочное масло растапливают и
фильтруют. Манную крупу просеивают и подвергают магнитной сепарации,
томат-пасту пропускают через финишер и разбавляют водой до концентрации 12%
сухих веществ. Подготовленное сырье подают на разваривание и протирание.
Разваривание и
смешивание компонентов
Чтобы облегчить
протирание плодов, овощей, мяса, их предварительно разваривают барботирующим
паром. При нагревании протопектин растительного сырья переходит в пектин, и
ткань размягчается. Разваривание ведут в герметически закрытых аппаратах,
снабженных шнекообразной мешалкой.
При пуске в
аппарате создают паровую завесу, чтобы вытеснить воздух. Это обеспечивает
сохранение витаминов плодов и овощей при переработке, а также предохраняет
продукт от потемнения. После вытеснения воздуха через люк, находящийся на
крышке аппарата, загружают подготовленное сырье, затем люк герметически
закрывают. Мешалку во избежание ее деформации включают не сразу, а через 5-10
мин после начала процесса, когда ткань сырья успеет размягчиться.
Температуру
разваривания устанавливают с учетом плотности ткани сырья и кислотности.
Кислота способствует гидролизу протопектина, ускоряя разваривание. Плоды,
ягоды, томаты, кабачки, шпинат, щавель, а также смесь овощей с жидкими
компонентами и мясо измельченное с бульоном разваривают при температуре 100°С,
тыкву, зеленый горошек, цветную капусту - при 105°С, морковь резаную и смесь
овощей - при 110°С, свеклу, картофель смесь овощей с мясом - при 120°С.
Продолжительность
процесса разваривания для разных видов исходных материалов различна и
составляет от 5 до 50 мин. Во время разваривания продукт разбавляется
конденсатом. Количество конденсата зависит от вида сырья и продолжительности
процесса шпарки и составляет от 16 до 25% к его массе. Разваривание -
длительный периодический процесс.
Конденсат,
образующийся при обработке плодов, овощей, мяса острым паром, разбавляет
продукт, который приходится уваривать. Продолжительное нагревание продукта
ухудшает его качество, поэтому вместо разваривания применяют также измельчение
и подогревание при температуре 90-100°С для овощей и 70-80°С для плодов. Жидкие
компоненты (молоко, бульон, рассол, сахарный сироп, томат-пюре, молоко с
протертой манной крупой, мукой, рисом) добавляют к основному продукту при
помощи насосов-дозаторов и после смешивания протирают. Протертую массу
перекачивают насосом в герметически закрытый сборник-подогреватель, который
оборудован мешалкой для смешивания компонентов консервов.
Гомогенизация массы
Полученное после
протирочной машины пюре имеет грубоволокнистое строение. Размеры частиц ткани
зависят от вида продукта и от диаметра отверстий в ситах протирочных машин и
составляют после первого протирания 150-550, а после финишера - 50-250 мкм.
Для придания продукту
более тонкого измельчения, улучшающего вкусовые качества, протертую массу
гомогенизируют, доводя дисперсность продукта до 20-30 мкм. Такой продукт хорошо
усваивается детским организмом, имеет однородную, кремообразную консистенцию и
не расслаивается при хранении консервов.
Деаэрация
Пюреобразные
консервы для детей деаэрируют, выдерживая массу в вакуум-аппарате в течение
10-20 мин. Одновременно в греющую камеру вакуум-аппарата подают пар. При этом
продукт закипает, вместе с водяными парами удаляется от 65 до 93% содержащегося
в нем воздуха. После деаэрации вакуум нарушается за счет выделения соковых
паров, температуру массы доводят до 80°С. В обработанном таким образом продукте
остается не более 1% воздуха по объему.
Фасовка, укупорка и
стерилизация
Перед фасовкой
продукт подогревают до температуры 70°С в непрерывно действующих
теплообменниках или в подогревателях периодического действия.
Фасовку производят
из закрытого сборника-подогревателя, снабженного мешалкой. В сборнике
поддерживается требуемая при фасовке продукта температура (70°С). Пюре фасуют в
стеклянные или жестяные лакированные банки (0,1-0,2 л), либо тубы при помощи
автоматических наполнителей.
Наполненную тару
немедленно закатывают, а затем стерилизуют: фруктовое или ягодное пюре при
100°С (из черной смородины - при 85°С), такое же пюре с добавлением круп и
молока - при 110-120°С, плодово-овощное, овощное, мясоовощное пюре - при 120°С.
Продолжительность собственно стерилизации в зависимости от вида продукта и тары
составляет от 10 до 60 мин. После стерилизации консервы охлаждают.
.5 Факторы сохраняющие
качество детского питания
Стойкость консервов при хранении
зависит от положения банок и температуры хранения. Если при транспортировке
банки перемещают, то нарушается их временная герметичность, микроорганизмы
освобождаются от других частиц и перемещаются внутри банок. При этом в
консервах, которые долго хранились в штабелях, может возникнуть
микробиологический бомбаж.
При температуре от 0 до 15°С и
относительной влажности воздуха 75% консервы мясные и мясорастительные с
томатной заливкой, квашеной капустой в цельноштампованных банках на
предприятиях общественного питания можно хранить до 30 суток. В сборных банках
при этих же условиях на холоде - 1,5 года, в стеклянных - 2 года. Срок хранения
мясных консервов с крупами, макаронными изделиями, овощами в цельноштампованных
банках до 2-х лет, сборных и стеклянных банках до 3-х лет.
По истечению срока хранения
пригодность консервов для пищевых целей устанавливают на основе
органолептического, бактериологического и химического анализов (определяют
массовую долю солей олова, прочих металлов и некоторые другие показатели) в
пищевых лабораториях санэпидемстанций.
Мясные детские консервы хранят в
охлаждаемых и неохлаждаемых складах. Ящики с консервами укладывают в штабеля,
нижний слой ящиков устанавливают на деревянных рейках или поддонах. Отступы от
стен, потолка, приборов охлаждения и размеры проездов должны быть такими же,
как и при хранении других продуктов питания в таре. Норма загрузки: 0,6 тонны на
1 м2 грузового объема камеры для хранения.
Хранят консервы при температуре от 0
до 15°С и относительной влажности воздуха не выше 75%. При более высокой
температуре хранения и относительной влажности воздуха возрастает скорость
коррозии и разрушения консервной тары, ухудшается качество продукта.
Для предохранения банок от коррозии
снаружи их лакируют или смазывают техническим вазелином. Чтобы банки не
отпотевали, перепад между температурой консервов и температурой окружающей
среды не должен превышать 3°С.
Замораживание мясных и овощных
консервов нежелательно, хотя, по данным рядя исследований, замораживание не
ухудшает их качеств.
Минусовые температуры при хранении и
транспортировке банок с мясными консервами, содержащими большое количество
жидких наполнителей, часто приводит к физическому бомбажу и нарушению
герметичности банок.
За 2-3 суток перед выпуском
консервов из холодильника в теплое время года их необходимо помещать в камеры с
температурой 10-15°С и с усиленной циркуляцией воздуха, чтобы предупредить
увлажнение и коррозию жестяных банок.
В магазинах детские консервы
необходимо хранить в сухих, хорошо вентилируемых помещениях или камерах с
температурой 0-20°С и относительной влажностью воздуха не выше 75% не более 30
суток. При длительном хранении консервов на складе или в магазине периодически
проверяют запасы и отбраковывают бомбажные, с подтеками или сильно
деформированные банки.
Банки должны быть чистыми, без
подтеков, без вздутых и хлопающих крышек, помятостей, фальцев, ржавчины и
бомбажа, без деформации корпуса и крышек и деформации в виде уголков у бортиков
банки, резина или паста не должны выступать из-под фальца, донышки должны быть
вогнутыми или плоскими, лакированные банки должны быть покрыты сплошным слоем
термоустойчивого лака. Стеклянные банки должны быть прозрачными, чистыми, без
внутренних и поверхностных пузырей, заусенцев и щербин. Корпус банки должен
быть гладким, без выпуклостей и вдавленностей, с равномерной толщиной стенок.
Допускается темно-зеленый цвет стекла, незначительные складки и волнистость.
Банки с налетом ржавчины, удаляемой при протирке сухой ветошью, подрабатывают и
принимают на хранение. Если на банках после удаления ржавчины и смазки
вазелином остаются темные пятна, то их после подработки реализуют в первую
очередь по разрешению органов санитарного надзора.
Ассортимент питания для детей дает
возможность на протяжении всего года обеспечить детей блюдами.
Овощные и фруктовые консервы для
детей изготовляют из отборных овощей и фруктов в специальных цехах консервных
заводов, с соблюдением особо тщательного санитарного и лабораторного контроля.
Оборудование для производства детского питания и производственные мощности
развернуть не так просто, поскольку к такому производству предъявляются
повышенные требования по контролю за качеством.
2. Методы и результаты
исследования проведения экспертизы качества продуктов детского питания на
примере ООО «Оптовик» гипермаркета «Эссен»
.1 Объекты исследования
Экспертизе качества подвергались
образцы однокомпонентного яблочного пюре, приготовленного на производстве и в
домашних условиях. В соответствии со схемой исследований начальным этапом
экспертизы являлась оценка целостности и анализ маркировки на потребительской
упаковке образцов яблочного пюре.
Все образцы яблочного пюре расфасованы
в стеклянные банки массой от 110 до 130 гр. По массе нетто все образцы имеют
незначительные отклонения, которые укладываются в допуск стандарта.
Таблица 7. Характеристика образцов
экспертизы
|
Наименование показателя
|
Образцы однокомпонентного яблочного пюре
|
|
|
|
«Бабушкино лукошко»
|
«Агуша»
|
«Фрутоняня»
|
«NUTRICIA»
|
«Gerber»
|
«HiPP»
|
|
Наименование продукта
|
Пюре фруктовое гомогенизированное стерилизованное
|
Пюре яблочное натуральное гомогенизированное стерилизованное
|
Пюре яблочное натуральное для питания детей раннего возраста
гомогенизированное, стерилизованное
|
Пюре гомогенизированное на фруктовой основе: яблоко
|
Фруктовое пюре «Яблоко» гомогенизировано, пастеризовано
|
Пюре яблочное витаминизированное, гомогенизированное,
стерилизованное. Органический продукт
|
|
Наименование и местонахождение изготовителя
|
ООО «Завод детского питания «Фаустово», Россия, Московская
область, Воскресенский район, поселок Белозерский, ул. Пионерская
|
ОАО «Вимм-Биль-Данн», Россия, г.Москва, Дмитровское шоссе, д.108
|
ОАО «Прогресс», Россия, г. Липецк, ул. Ангарская
|
Завод «Nutricia Deva
a.s., Чешская
Республика
|
Nestle,
Польша
|
ООО «Хипп», Россия, Калиниградская область, Баратиновский район,
г. Мамоново, ул. Таможняя, 40
|
Исходя из данных таблицы мы
приступаем к оценке качества данных образцов товаров.
2.2 Результат анализа
состояния упаковки и маркировки исследуемых образцов (на примере детского
питания)
Основные информационные
характеристики исследуемых образцов представлены в таблице 8 Маркировка имеет
четкий текст и иллюстрации, по полноте информации соответствует нормативным
требованиям ГОСТ Р 51074-2003 «Продукты пищевые. Информация для потребителей.
Общие требования». Вся продукция является сертифицированной. (Изменение №2 к ГОСТ Р 510074-2003 от
01.07.2013)
Анализ маркировки показал, что у
всех образцов калорийность, заявленная на маркировке, не соответствует
расчетной. На маркировке образца яблочного пюре торговой марки «HiPP» отсутствует информация
об энергетической ценности. На маркировке пюре торговых марок «NUTRICIA» и «Gerber» отсутствует
обозначение нормативного документа в соответствии с которым оно было
изготовлено, но ввиду того, что данные образцы являются продуктами импортного
производства, мы не можем дать заключение, что этот факт является нарушением
российского ГОСТ Р 51074 - 2003 «Продукты пищевые. Информация для потребителей.
Общие требования». (Изменение №2 к ГОСТ Р 51074-2003 от 01.07.2013)
Таким образом, выявленные при
анализе маркировки замечания являются не существенными и в целом маркировка
соответствует требованиям ГОСТ Р 51074 - 2003 «Продукты пищевые. Информация для
потребителей. Общие требования».
2.3
Органолептические методы и результат исследования
Органолептические показатели
качества яблочного пюре для питания детей раннего возраста играют важную роль в
формировании предпочтений потребителей и выборе ими конкретного производителя.
Эти показатели зависят от качества сырья, технологии производства, условий
хранения и др. факторов, оказывающих влияние на формирование и изменение
органолептических показателей качества яблочного пюре (таблица 12).
Оценка образцов яблочного пюре по
100 - балльной шкале выявила различия между образцами по внешнему виду, цвету и
консистенции. По результатам дегустации установлено, что образцы импортного
производства получили более высокие оценки, чем образцы отечественного
производства. Из образцов отечественного производства наибольшее количество
баллов -95,7 - получил образец торговой марки «Фрутоняня» за приятный вкус и
нежную консистенцию. Яблочное пюре домашнего приготовления по вкусу, запаху,
цвету и консистенции соответствовало требованиям стандарта, но дегустаторами
был отмечен более выраженный кислый вкус, за что данный образец получил
наименьшее количество баллов.
С помощью приложение 2 мы наглядно
можем просмотреть маркировку выбранных образцов детского питания, а также ее
соответствие принятым Гостам.
С помощью таблицы 9 мы провели
оценку качества образцов детского питания по внешнему виду, консистенции,
цвету, вкусу, запаху.
Таблица 9. Дегустационная оценка
качества образцов яблочного пюре
|
Торговая марка образца яблочного пюре
|
Внешний вид
|
Консистенция
|
Цвет
|
Вкус
|
Запах
|
Комплексный показатель качества
|
|
«Бабушкино лукошко»
|
4,3±0,4
|
4,7±0,3
|
4,5±0,5
|
4,8±0,5
|
5,0±0
|
92,6
|
|
«Агуша»
|
4,8±0,5
|
4,5±0,8
|
4,8±0,5
|
4,8±0
|
4,3±0
|
93,8
|
|
«Фрутоняня»
|
5,0±0
|
5,0±0
|
4,9±0,3
|
4,5±0,5
|
4,5±0,5
|
95,7
|
|
«NUTRICIA»
|
5,0±0
|
4,7±0,5
|
5,0±0
|
4,9±0,3
|
4,7±0,3
|
98,2
|
|
«Gerber»
|
5,0±0
|
4,9±0,3
|
5,0±0
|
4,9±0,3
|
4,2±0,8
|
97,4
|
|
«HiPP»
|
4,9±0,3
|
4,6±0,5
|
4,9±0,5
|
5,0±0
|
4,5+0,4
|
96,9
|
|
Домашнее пюре из яблок
|
4,6±0,3
|
4,4±0,5
|
5,0±0
|
4,2±0
|
5,0±0
|
90,8
|
2.4 Физико-химические
методы и результат исследования
При сравнении физико-химических
показателей качества яблочного пюре были выявлены некоторые особенности
производства консервов для детского питания, которые не указаны на этикетке
(таблица 10).
Таблица 10. Результаты
физико-химических исследований образцов
|
Наименование образца
|
Массовая доля сухих веществ, %
|
Титруемая кислотность, %
|
Массовая доля водораствори-мых сухих веществ,%
|
Сахароза,%
|
Пектин,%
|
Витамин С, мг/%
|
|
«Бабушкино лукошко»
|
16,0
|
0,3
|
9,7
|
6,5
|
0,8
|
3,1
|
|
«Агуша»
|
14,0
|
0,3
|
11,7
|
11,1
|
0,3
|
3,5
|
|
«Фрутоняня»
|
16,0
|
0,3
|
11,4
|
14,3
|
0,4
|
2,2
|
|
«NUTRICIA»
|
0,3
|
12,9
|
4,0
|
0,8
|
13,7
|
|
«Gerber»
|
12,0
|
0,3
|
10,5
|
4,2
|
0,8
|
14,3
|
|
«HiPP»
|
14,0
|
0,3
|
8,6
|
3,6
|
0,6
|
15,0
|
|
Домашнее пюре из яблок
|
12,0
|
0,2
|
8,1
|
3,0
|
0,8
|
1,8
|
По данным таблицы 10, кислотность
всех образцов оказалась в пределах, установленных ГОСТ (0,2-0,8%). Количество
растворимых сухих веществ - комплексный показатель, который отражает, прежде
всего, количество растворимых углеводов (норма по нормативным документам - не
менее 9%). Содержание углеводов и их состав в яблоках - не постоянный признак и
зависит от многих условий. Например, в связи с тепловой обработкой часть
углеводов может теряться. В исследуемых образцах норма массовой доли сухих
веществ была выдержана.
Количество сахарозы в яблочном пюре
не нормируется, но в среднем ее содержание в сырье должно составлять 7-12%.
Яблочное пюре домашнего производства было изготовлено из яблок зимнего периода,
в которых ее содержалось составило - 3,0%. Анализ результатов таблицы позволяет
сделать вывод о том, что в состав пюре торговой марки «Фрутоняня» добавлен
сахар, хотя на этикетке данный факт не отмечен. Дегустаторы также отметили
очень сладкий вкус данного образца яблочного пюре. Лишь в пюре домашнего производства
и пюре торговых марок «Gerber», «NUTRICIA» и «HiPP» сахар отсутствовал.
Содержание витамина С в яблоках
подвержено изменениям в зависимости от разных факторов и, в целом, оно не
высоко. На маркировке яблочного пюре торговых марок «Фрутоняня», «NUTRICIA», «HiPP» и «Gerber» указано, что они
изготовлены с добавлением витамина С. Тем не менее, из результатов экспертизы
видно, что производитель яблочного пюре торговой марки «Фрутоняня» забыл об
этом условии.
Пектин - полисахарид, который
содержится в яблоках. По его содержанию можно судить, сколько натурального
сырья содержат консервы из яблочного пюре. С небольшим содержанием натурального
сырья оказались образцы яблочного пюре торговых марок «Агуша» и «Фрутоняня».
Содержание водорастворимых сухих веществ варьировало от 8,1 до 12,9%. Чтобы
выяснить, чем обусловлено высокое содержание сухих веществ в консервах, было
исследовано наличие крахмала (таблица 14).
Результаты качественной реакции на
крахмал выявили следующее: при изготовлении яблочного пюре торговых марок
«Фрутоняня», «Бабушкино лукошко», «Агуша» и «HiPP» использовался
загуститель крахмал, который плохо усваивается детским организмом, и в составе
яблочного пюре данный компонент не указан, что свидетельствует об
информационной фальсификации.
Таблица 11. Результаты качественной
реакции на крахмал
|
Образцы яблочного пюре
|
|
«Фрутоняня»  крахмал присутствует крахмал присутствует
|
«Бабушкино лукошко»  крахмал присутствует крахмал присутствует
|
«Агуша»  крахмал
присутствует крахмал
присутствует
|
|
Состав продукта: без крахмала и сахара
|
Состав продукта: без сахара и загустителей.
|
Состав продукта: не содер-жит крахмал и сахар
|
|
«Gerber»
крахмал
отсутствует крахмал
отсутствует
|
«NUTRICIA»
 крахмал
отсутствует крахмал
отсутствует
|
«HiPP»  крахмал
присутствует крахмал
присутствует
|
|
Состав продукта: без до-бавления крахмала и сахара
|
Состав продукта: без крах-мала
|
Состав продукта: не содер-жит крахмала,
|
Исходя из данных таблицы 11,
яблочное пюре для питания детей раннего возраста промышленного производства
является хорошей альтернативой пюре домашнего производства, приготовленного в
зимний период, но не один из анализируемых образцов не может являться
качественным. Производители яблочного пюре торговых марок «Фрутоняня», «Бабушкино
лукошко», «Агуша» и «HiPP» пользовались информационной фальсификацией, не указав в составе
крахмал. Производители яблочного пюре торговой марки «Фрутоняня» добавили
сахар, несмотря на информацию на этикетке - «Без сахара». Особенно в обмане
отличился производитель яблочного пюре торговой марки «Фрутоняня», который
помимо всех выше перечисленных недостатков, «забыл» добавить в пюре обещанный
на этикетке витамин С.
Статистическая обработка результатов
измерений является завершающей стадией количественного анализа химического
состава любого продукта. Она позволяет оценить систематические и случайные
погрешности измерений.
При химическом анализе пищевых
продуктов содержание вещества в пробе устанавливают, как правило, по небольшому
числу параллельных определений.
Оценка воспроизводимости результатов
измерений.
Среднее выборки. Пусть х1,х2,…хn обозначают n результатов измерений величины, истинное значение которой µ.
Предполагается, что все измерения проделаны одним методом и с одинаковой
точностью. В теории ошибок доказывается, что при условии выполнения нормального
закона при n измерениях одинаковой точности среднее арифметическое из
результатов, полученных при всех измерениях, является наиболее вероятным и
наилучшим значением измеряемой величины:
Х=(х1+х2+…+хj+…+хn)/n=1/n∑хj, 1.
Это среднее значение принимают
приближенно и пишут Х≈µ.
Единичное отклонение- это отклонение
отдельного измерения от среднего арифметического:
Еj=хj-х, 2.
Алгебраическая сумма единичных
отклонений равна нулю:
∑Еj=0, 3.
Рассеяние результатов измерений
относительно среднего значения принято характеризовать стандартным отклонением
(средним квадратичным отклонением) - S, которое обычно приводят при представлении результатов измерений
и которым характеризуют их воспроизводимость:
S=√∑(хj-х)2/n-1, 4.
Стандартное отклонение, деленное на
среднее выборки, называют относительным стандартным отклонением:
Sr=S\х, 5.
В общем случае метод анализа
оптимален в той области содержаний, в которой и абсолютное (S) и относительное (Sr) стандартные
отклонения имеют минимальные значения.
Таблица 12. Определение массовой
доли сухих веществ в образцах яблочного пюре с учетом статистических данных
|
Наименование торговой марки
|
Массовая доля сухих веществ, %
|
Среднее арифметическое из результатов, Х
|
Единичное отклонение, Е
|
Стандартное отклонение, S
|
Относительное стандартное отклонение, Sr
|
|
повторности
|
|
|
|
|
|
Первая
|
Вторая
|
|
|
|
|
|
«Бабушкино лукошко»
|
16,3
|
15,7
|
16,0
|
0,3
|
0,4
|
0,03
|
|
«Агуша»
|
12,0
|
16,0
|
14,0
|
2,0
|
2,8
|
0,2
|
|
«Фрутоняня»
|
15,0
|
14,0
|
16,0
|
1,0
|
1,4
|
0,09
|
|
«NUTRICIA»
|
10,0
|
10,0
|
10,0
|
0
|
0
|
0
|
|
«Gerber»
|
11,8
|
12,2
|
12,0
|
0,2
|
0,28
|
0,02
|
|
«HiPP»
|
11,0
|
17,0
|
14,0
|
3,0
|
4,2
|
0,3
|
|
Домашнее пюре из яблок
|
11,6
|
12,4
|
12,0
|
0,6
|
0,8
|
0,07
|
Данные таблицы 12 показывают нам
массовую долю сухих веществ в каждом образце детского питания
Таблица 13. Определение титруемой
кислотности в образцах пюре с учетом статистических данных
|
Наименование торговой марки
|
Титруемая кислотность, %
|
Среднее арифметическое из результатов, Х
|
Единичное отклонение, Е
|
Стандартное отклонение, S
|
Относительное стандартное отклонение, Sr
|
|
повторности
|
|
|
|
|
|
Первая
|
Вторая
|
|
|
|
|
|
«Бабушкино лукошко»
|
0,25
|
0,35
|
0,3
|
0,05
|
0,07
|
0,2
|
|
«Агуша»
|
0,2
|
0,4
|
0,3
|
0,1
|
0,14
|
0,5
|
|
«Фрутоняня»
|
0,3
|
0,3
|
0,3
|
0
|
0
|
0
|
|
«NUTRICIA»
|
0,4
|
0,2
|
0,3
|
0,1
|
0,14
|
0,5
|
|
«Gerber»
|
0,15
|
0,45
|
0,3
|
0,15
|
0,2
|
0,7
|
|
«HiPP»
|
0,3
|
0,3
|
0,3
|
0
|
0
|
0
|
|
Домашнее пюре из яблок
|
0,14
|
0,34
|
0,2
|
0,06
|
0,08
|
0,4
|
Данные таблицы 13 позволяют
определить уровень тестируемой кислотности в образцах пюре.
Таблица 14. Определение массовой
доли водорастворимых сухих веществ в образцах пюре с учетом статистических
данных
|
Наименование торговой марки
|
Массовая доля водорастворимых сухих веществ, %
|
Среднее арифметическое из результатов, Х
|
Единичное отклонение, Е
|
Стандартное отклонение, S
|
Относительное стандартное отклонение, Sr
|
|
повторности
|
|
|
|
|
|
Первая
|
Вторая
|
|
|
|
|
|
«Бабушкино лукошко»
|
10,0
|
9,4
|
9,7
|
0,3
|
0,4
|
0,04
|
|
«Агуша»
|
12,0
|
11,4
|
11,7
|
0,3
|
0,4
|
0,03
|
|
«Фрутоняня»
|
11,5
|
11,3
|
11,4
|
0,1
|
0,14
|
0,01
|
|
«NUTRICIA»
|
13,0
|
12,8
|
12,9
|
0,1
|
0,14
|
0,01
|
|
«Gerber»
|
10,3
|
10,7
|
10,5
|
0,2
|
0,3
|
0,03
|
|
«HiPP»
|
8,4
|
8,8
|
8,6
|
0,2
|
0,3
|
0,03
|
|
Домашнее пюре из яблок
|
8,0
|
8,2
|
8,1
|
0,1
|
0,14
|
0,02
|
Данные таблицы 14 показывают, что в
Образце №4 массовая доля водорастворимых сухих веществ больше, чем в других, а
в образце №6, наименьшее количество содержания данных веществ.
Таблица 15. Определение пектина в
образцах пюре с учетом статистических данных
|
Наименование торговой марки
|
Пектин,%
|
Среднее арифметическое из результатов, Х
|
Единичное отклонение, Е
|
Стандартное отклонение, S
|
Относительное стандартное отклонение, Sr
|
|
повторности
|
|
|
|
|
|
Первая
|
Вторая
|
|
|
|
|
|
«Бабушкино лукошко»
|
0,7
|
0,9
|
0,8
|
0,1
|
0,14
|
0,2
|
|
«Агуша»
|
0,24
|
0,36
|
0,3
|
0,04
|
0,06
|
0,2
|
|
«Фрутоняня»
|
0,4
|
0,4
|
0,4
|
0
|
0
|
0
|
|
«NUTRICIA»
|
0,6
|
1,0
|
0,8
|
0,2
|
0,3
|
0,4
|
|
«Gerber»
|
0,8
|
0,8
|
0,8
|
0
|
0
|
0
|
|
«HiPP»
|
0,5
|
0,7
|
0,6
|
0,1
|
0,14
|
0,2
|
|
Домашнее пюре из яблок
|
0,75
|
0,85
|
0,8
|
0,05
|
0,07
|
0,1
|
Таблицы 15 показывает содержание
пектина в образцах детского питания.
В образце №2 наименьшее количество
пектина, в образце №4 наибольшее количества данного вещества.
Таблица 16. Определение сахарозы в
образцах пюре с учетом статистических данных
|
Наименование торговой марки
|
Сахароза,%
|
Среднее арифметическое из результатов, Х
|
Единичное отклонение, Е
|
Стандартное отклонение, S
|
Относительное стандартное отклонение, Sr
|
|
повторности
|
|
|
|
|
|
Первая
|
Вторая
|
|
|
|
|
|
«Бабушкино лукошко»
|
6,4
|
6,6
|
6,5
|
0,1
|
0,14
|
0,02
|
|
«Агуша»
|
11,0
|
11,2
|
11,1
|
0,1
|
0,14
|
0,01
|
|
«Фрутоняня»
|
14,5
|
14,1
|
14,3
|
0,2
|
0,3
|
0,02
|
|
«NUTRICIA»
|
3,0
|
5,0
|
4,0
|
1,0
|
1,4
|
0,4
|
|
«Gerber»
|
4,0
|
4,4
|
4,2
|
0,2
|
0,3
|
0,07
|
|
«HiPP»
|
3,4
|
3,8
|
0,2
|
0,3
|
0,08
|
|
Домашнее пюре из яблок
|
3,0
|
3,0
|
3,0
|
0
|
0
|
0
|
Данные таблицы 16 показывают содержание
сахарозы в образцах детского питания. В образце №3 наибольшее количество
сахарозы. В образце № 6 содержится наименьшее количество данного вещества.
Таблица 17. Определение содержания
витамина С в образцах пюре с учетом статистических данных
|
Наименование торговой марки
|
Витамин С, мг%
|
Среднее арифметическое из результатов, Х
|
Единичное отклонение, Е
|
Стандартное отклонение, S
|
Относительное стандартное отклонение, Sr
|
|
повторности
|
|
|
|
|
|
Первая
|
Вторая
|
|
|
|
|
|
«Бабушкино лукошко»
|
3,0
|
3,2
|
3,1
|
0,1
|
0,14
|
0,05
|
|
«Агуша»
|
3,3
|
3,7
|
3,5
|
0,2
|
0,3
|
0,08
|
|
«Фрутоняня»
|
2,0
|
2,4
|
2,2
|
0,2
|
0,3
|
0,1
|
|
«NUTRICIA»
|
13,5
|
13,9
|
13,7
|
0,2
|
0,3
|
0,02
|
|
«Gerber»
|
14,0
|
14,6
|
14,3
|
0,3
|
0,4
|
0,03
|
|
«HiPP»
|
15,0
|
15,0
|
15,0
|
0
|
0
|
0
|
|
Домашнее пюре из яблок
|
1,6
|
2,0
|
1,8
|
0,2
|
0,3
|
0,2
|
Данные таблиц 12-17 свидетельствуют
о том, что все результаты статистической обработки измерений минимальны,
следовательно, измерения произведены правильно. Статистическая обработка данных
измерений свидетельствует о достоверности проведенных физико-химических
анализов качества анализируемых образцов яблочного пюре.
3. Анализ обеспеченности
торгового предприятия инвентарем и торгово-технологическим оборудованием на
примере ООО «Оптовик» гипермаркета «Эссен»
Эссен» позиционирует себя как
гипермаркет эконом-класса, средний чек в котором около 725 руб.
ЭССЕН - это крупнейшая сеть
гипермаркетов в Республике Татарстан, постоянно осваивающая новые города и
регионы.
В 2003 г. открылся первый
гипермаркет ЭССЕН. В 2009 г. насчитывается 12 гипермаркетов в 9 городах
Республики Татарстан и Кировской области. Оборот компании в 2008г. составил 5,5
млрд. рублей. Количество сотрудников - 2500 человек. Ассортимент товара - 15000
наименований. Ежедневно в сети ЭССЕН совершают покупки 80 тыс. покупателей.
Под одной крышей покупатели могут не
только купить товары, но и оплатить сотовую связь, воспользоваться услугами
банкомата, приобрести необходимые медикаменты. Низкие цены всегда выделяют
данную компанию среди конкурентов. Четкие бизнес-процессы и низкие затраты на
складирование продукции позволяют продавать товар с очень низкой наценкой.
Прежде всего, следует отметить, что
стратегия гипермаркета ЭССЕН может быть охарактеризована как стратегия
ограниченного роста. Необходимо произвести анализ внешней и внутренней среды
компании для оценки возможных вариантов оптимизации стратегии.
В торговом зале магазинов ООО
«Эссен» 15 отделов:
1. Промтовары (бытовая химия)
2. Напитки, соки, воды
. Рыба и полуфабрикаты
. Бакалейный отдел (крупы)
. Кондитерский отдел
. Отдел диетического питания
. Отдел детского питания
. Чай и кофе
. Отдел фруктов
. Колбасы и мясные изделия
. Отдел молочных продуктов
. Отдел салатов и выпечки
. Вино-водочная продукция
. Гастрономический отдел
. Хлебобулочные изделия
Деятельность ООО «Эссен»
регулируется:
− Гражданским кодексом
РФ;
− Налоговым кодексом РФ;
− Трудовым кодексом РФ;
− Федеральным законом
«Об обществах с ограниченной ответственностью»;
− Федеральном законом «О
защите прав потребителей»;
− Правилами торговли;
− Уставом предприятия и
другими нормативно-правовыми актами.
Важной функцией управления является
функция организации, которая заключается в установлении постоянных и временных
взаимоотношений между всеми подразделениями фирмы, определении порядка и
условий функционирования фирмы. Функция организации реализуется двумя путями:
через административно-организационное управление и через оперативное
управление.
Круг обязанностей, который выполняет
каждый работник по своей должности, определяется должностными инструкциями. В
ТЦ «Эссен» имеются должностные инструкции на весь персонал.
Общая площадь магазина составляет:
714,3 м2, из которых торговая занимает 400 м2 (площадь для дополнительного
обслуживания покупателей отсутствует)
Количество разгрузочных мест: 4.
Таблица 18. Структура площадей
магазина:
|
Группа помещений:
|
Расчетная площадь м2
|
Удельный вес%
|
|
1Торговая площадь
|
363
|
56
|
|
1,1 Торговый зал
|
363
|
56
|
|
2 Неторговая площадь
|
248,6
|
34,8
|
|
2,1 Помещения для приемки, хранения и подготовки товаров к
продаже
|
100
|
15,4
|
|
2,2 Помещения хозяйственного обслуживания оперативных процессов
|
70
|
10,8
|
|
2,3 Административно- бытовые помещения
|
55
|
8,6
|
|
3Ненормируемуе площади
|
60
|
9,2
|
|
Общая площадь магазина
|
714,3
|
100
|
Таблица 19. Состав и площади
помещений хозяйственного обслуживания оперативных процессов в магазинах
|
Помещения хозяйственного обслуживания оперативных процессов
|
Площадь помещений, м2
|
|
Хранение тары
|
18
|
|
Помещение для хранения упаковочных материалов, инвентаря и
спецодежды
|
5
|
|
Помещение для хранения уборочного инвентаря, моющих и
дезинфицирующих средств
|
7
|
|
Моечная
|
6
|
|
Помещение для мусора
|
5
|
|
Помещение для приема стеклотары
|
29
|
Таблица 20. Состав и площади
административно- бытовых помещений в магазинах
|
Административно- бытовые помещения
|
Площадь помещений, м 2
|
|
Кабинет директора
|
6
|
|
комната персонала
|
20
|
|
Помещение охраны
|
6
|
|
Гардеробные
|
15
|
|
Уборные
|
8
|
«Эссен» расположен в отдельно
стоящем одноэтажном здании. Имеются стоянки для личного автотранспорта
покупателей. Зона расположения магазина характеризуется достаточной пешеходной
проходимостью. В магазине имеются подсобные помещения, помещения для хранения,
приемки и подготовке товаров к продаже), помещения хозяйственного обслуживания
оперативных процессов, а также административно- бытовые помещения.
Расчет эффективности использования
площади торгового зала:
Произведем расчет коэффициентов
установочной площади торгового зала:
Ку= Sy/Sт.з.= 110,134/ 363= 0,30 6.
Магазин «Эссен» осуществляет
индивидуальное обслуживание покупателей через прилавок отсюда следует, что
коэффициент установочной площади должен быть равен 0.15. Однако на практике мы
получаем коэффициент, равный 0.30. Это говорит об излишней заставленности
площади торгового зала, что повлечет за собой неудобство в свободном
перемещении покупателей в гастрономе. Для более рационального использования
площадей необходимо уменьшить количество единиц оборудования.
Кэ=Sэ/Sт.з. =308,198/363=0,85 7.
Значение экспозиционной площади,
равное 0,85 превышает допустимый показатель, что говорит о большом количестве
товаров, хранящихся в торговом зале. Это вызывает неудобство при выкладке,
выборе и обзоре товара
Произведем расчет необходимого
количества ККМ для ТЦ «Эссен»
При выборе ККМ необходимо точно
знать какое их количество нужно для данного предприятия. Расчет требуемого
количества ККМ может быть выполнен двумя способами:
) с помощью Примерных норм технического
оснащения предприятий торговли с учетом торговой площади магазина. Этот метод
применим для новых (типовых) магазинов, строительство которых отвечает
строительным нормам и правилам проектирования (СНиП11-77-80. Магазины. Нормы
проектирования);
) расчетным методом, который
используется для определения потребности в ККМ нетиповых магазинов, т.е. в тех
случаях, когда торговые залы предприятий после реконструкции или капитального
ремонта не отвечают строительным нормам и правилам проектирования.
Порядок определения потребности в
ККМ расчетным способом следующий.
. Определяют среднее число
посетителей, сделавших "покупку" в час, по формуле
nСР= ТО/(СtС),
8.
где nСР - среднее число посетителей, сделавших "покупку" в час;
ТО - среднестатистический
товарооборот в смену, руб.; С -
среднестатистическая стоимость "покупки", приходящаяся на одного
покупателя, руб.; tС - число часов работы магазина в смену, ч.
. Определяют пропускную способность
узла расчета по формуле
Р = 3600КИ/Dt = 3600 КИ /(р Dt¢ + Dt²), 9.
где Р - пропускная способность узла
расчета, чел. в час; КИ - коэффициент использования рабочего времени кассира, равный 0,7; р
- среднее количество товарных единиц,
приходящихся на одного покупателя, шт. (в зависимости от местонахождения
магазина и ассортимента товаров составляет от 4 до 6 единиц); Dt¢ - средние затраты времени
на пробивку одной суммы (по одной товарной единице), с (принять: до 5 - 8 с - для электромеханических ККМ и до 1,5 - 2 с - для электронных ККМ); Dt² - средние затраты времени
на обслуживание одного покупателя (на считывание цен, прием денег и выдачу
сдачи и т.д.), с (принять от 25 до 30 с).
. Определяют расчетное количество
ККМ по формуле
Р = nСР /Р 10.
где NР - расчетное
количество ККМ.
. С учетом резервных ККМ определяют
общее число ККМ по формуле
ОБЩ = NР + NРЕЗ. 11.
где NОБЩ - общее число
ККМ; NРЕЗ - число резервных ККМ.
При проектировании новых магазинов
(по первому способу) число рабочих мест контролеров-кассиров рассчитывают
исходя из площади торгового зала по формуле
 , 12.
, 12.
где NР -
число рабочих мест контролеров; S - площадь торгового зала, м2; q - площадь
торгового зала, приходящаяся на одного покупателя (2,5 м2 согласно СНиП, п.
5.8); t - среднее время расчета с одним покупателем
(t = р Dt¢
+ Dt²,
здесь р, Dt¢
и Dt²
см. пояснения выше), с; К - коэффициент использования рабочего времени
контролера-кассира, равный 0,7.
Определим потребность в
ККМ ТЦ «Эссен» торговая площадь которого составляет 400 м2, средний
товарооборот которого составляет 200000 рублей в смену. Сумма среднего чека в
данном супермаркете составляет около 725 рублей. Рабочее время в день -
12часов.
1. nСР = 200000/725*12 = 23
13.
2. Р = 3600*0,7/(5*7 + 30) ≈
39 14.
. NР = 23/39 =
0,76 ≈ 1 15.
. NОБЩ = 4 16.
Таким образом, согласно расчетам
данному торговому предприятию необходимо иметь четыре контрольно-кассовые
машины.
Заключение
В настоящее время консервы для
питания детей раннего возраста прочно заняли свою нишу, как в зарубежных
странах, так и в нашей стране. За последние годы ассортимент их значительно
расширился, они пользуются большой популярностью и для вскармливания здоровых
детей, и детей с отклонениями в здоровье.
Результаты сравнительной оценки
качество образцов яблочного пюре промышленного производства и домашнего
приготовления выявили следующее:
. Анализ маркировки показал, что у
всех образцов яблочного пюре промышленного производства калорийность,
заявленная на маркировке, не соответствует расчетной. На маркировке образца
яблочного пюре торговой марки «HiPP» отсутствует информация об энергетической ценности. На маркировке
пюре торговых марок «NUTRICIA» и «Gerber» отсутствует обозначение нормативного документа в соответствие с
которым оно было изготовлено. Таким образом, выявленные при анализе маркировки
замечания являются не существенными и в целом маркировка соответствует
требованиям ГОСТ Р 51074 - 2003 «Продукты пищевые. Информация для потребителей.
Общие требования».
. Оценка образцов яблочного пюре
промышленного производства по 100 - балльной шкале выявила различия между
образцами по внешнему виду, цвету и консистенции. По результатам дегустации
установлено, что образцы импортного производства получили более высокие оценки,
чем образцы отечественного производства. Из образцов отечественного
производства наибольшее количество баллов -95,7 - получил образец торговой
марки «Фрутоняня» за приятный вкус и нежную консистенцию. Яблочное пюре
домашнего приготовления по вкусу, запаху, цвету и консистенции соответствовало
требованиям стандарта, но дегустаторами был отмечен более выраженный кислый
вкус, за что данный образец получил наименьшее количество баллов.
. Результаты экспертизы качества
яблочного пюре по физико-химическим показателям выявили, что яблочное пюре
промышленного производства является хорошей альтернативой пюре домашнего
производства, приготовленного в зимний период, но не один из анализируемых
образцов не может являться качественным. Производители яблочного пюре торговых
марок «Фрутоняня», «Бабушкино лукошко», «Агуша» и «HiPP» пользовались
информационной фальсификацией, не указав в составе крахмал. Производители
яблочного пюре торговой марки «Фрутоняня» добавили сахар, несмотря на
информацию на этикетке - «Без сахара». Особенно в обмане отличился
производитель яблочного пюре торговой марки «Фрутоняня», который помимо всех
выше перечисленных недостатков, «забыл» добавить в пюре обещанный на этикетке
витамин С.
. Наиболее конкурентоспособным
является яблочное пюре отечественного производства торговой марки «Фрутоняня».
Покупатели в большинстве случаев отдают предпочтение именно этой торговой
марки, что определяется приемлемой ценой по сравнению с яблочным пюре
импортного производства.
. Анализ ассортимента продуктов
детского питания показал, что из всего ассортимента продуктов детского питания,
наибольшую долю в обороте занимают соки - 24,4%, на втором месте каши - 21,5%.
Список используемой
литературы
1. Товароведение,
экспертиза и стандартизация: учебник для вузов / А. А. Ляшко - М.: Дашков и К,
2009. - 667 с.
2. Упаковка,
технология хранения и транспортирования непродовольственных товаров: терминал.
слов. / Федер. агентство по образованию, Краснояр. гос. торг. -экон. ин-т;
сост. Л. Н. Демина. - Красноярск: КГТЭИ, 2009. - 22 с.
. Измерительные
методы контроля показателей качества и безопасности продуктов питания. В 2 ч.
Ч. 2. Продукты животного происхождения: учеб. пособие для вузов / В. В.
Шевченко - СПб. Троицкий мост, 2009. - 199 с.
. Васильева Н. О.
Экспертиза непродовольственных товаров: конспект лекций для студентов
специальности 080401.65 всех форм обучения / Н. О. Васильева; Федер. агентство
по образованию, Краснояр. гос. торг. -экон. ин-т. - Красноярск: КГТЭИ, 2009. -
104 с.
. Меньшикова В.
К. Факторы, формирующие ассортимент и качество швейных и трикотажных товаров:
учеб. пособие для вузов по специальности 080401.65 всех форм обучения / В. К.
Меньшикова; Федер. агентство по образованию, Краснояр. гос. торг. -экон. ин-т.
- 2-е изд. - Красноярск: КГТЭИ, 2009. - 199 с.
. Набережных А.
И. Бытовые приборы времени: учеб. пособие для вузов / А. И. Набережных, В. В.
Ярабаев. - М.: Альфа-М: ИНФРА-М, 2010. - 381 с.
. Идентификация и
фальсификация непродовольственных товаров: учеб. пособие для вузов / ред. И. Ш.
Дзахмишева. - М.: Дашков и К, 2009. - 357 с.
. Товароведение и
экспертиза непродовольственных товаров: словарь-справочник / общ. ред. С. А.
Вилкова. - М.: Дашков и К, 2009. - 264 с.
. Голубенко О. А.
Товароведение непродовольственных товаров: учеб. пособие для сред. проф.
образования / О. А. Голубенко, В. П. Новопавловская, Т. С. Носова. - М.: Альфа-М:
ИНФРА-М, 2009. - 335 с.
. Паршикова В. Н.
Товароведение и экспертиза парфюмерно-косметических товаров: учеб. пособие по
специальности 080401.65 и направления 100800 / В. Н. Паршикова, О. Б. Горюнова,
Т. И. Чалых. - Красноярск: КГТЭИ, 2010. - 405 с.
. Технология мяса
и мясных продуктов: учебник для вузов: в 2 кн. / И. А. Рогов, А. Г. Забашта, Г.
П. Казюлин. - М.: КолосС, 2009 - 2009.
. Голубенко О. А.
Товароведение непродовольственных товаров: учеб. пособие для сред. проф.
образования / О. А. Голубенко, В. П. Новопавловская, Т. С. Носова. - М.:
Альфа-М: ИНФРА-М, 2010. - 335 с.
. Трыкова Т. А.
Товароведение упаковочных материалов и тары: учеб. пособие / Т. А. Трыкова. -
2-е изд. - М.: Дашков и К, 2010. - 209 с.
. Строительные
товары: метод. указания к самостоят. работе по дисциплине "Товароведение
непрод. товаров" для студентов специальностей 080402.51, 080302.51 всех
форм обучения / Федер. агентство по образованию, Краснояр. гос. торг. -экон.
ин-т, Отд-ние сред. проф. образования; сост. Л. Н. Самойлова. - Красноярск:
КГТЭИ, 2010. - 59 с.
. Калачев С. Л.
Товароведение и экспертиза транспортных средств личного пользования: учебник /
С. Л. Калачев. - М.: Дашков и К, 2011. - 311 с.
. Калачев С. Л.
Теоретические основы товароведения и экспертизы: учебник для вузов / С. Л.
Калачев. - М.: Юрайт, 2011. - 463 с. -
. Богатырев С. А.
Технология хранения и транспортирования товаров: учеб. пособие / С. А.
Богатырев, И. Ю. Михайлова. - 2-е изд. - М.: Дашков и К, 2010. - 143 с.
. Идентификационная
и товарная экспертиза хозяйственных и культурно-бытовых товаров: учебник: учеб.
пособие для вузов / ред. А. Н. Неверов, Т. И. Чалых. - М.: ИНФРА-М, 2010. - 413
с.
19. Арустамов Э.А.
Техническое оснащение торговых организаций: учебник для сред. проф.
образования. - М., Академия, 2011, 208 с.
20. Гайворонский
К.Я., Щеглов Н.Г. Технологическое оборудование предприятий общественного
питания и торговли: учебник для учащихся средних специальных учебных заведений.
- М., Форум, ИНФРА-М, 2008.
. Колупаева Т.Я.,
Агафонов Н.Н., Дзюба Г.Н., Стрельцов А.Н. Оборудование предприятий
общественного питания. Торговое оборудование.Часть 3. - М., Академия, 2010.
. А.А Вытовтов
Теоретические и практические основы органолептического анализа продуктов
питания: учеб. пособие /А.А Вытовтов.-СПБ.: Г/Лорд,2010.-232с.
. Идентификация и
товарная экспертиза продуктов белкового питания и пищевых жиров: Учебник /
Под.ред.проф. Т.Г.Родиной. - М.: ИНФРА - М.2010. - 544с.
. Пастерных М.С
Товароведение и экспертиза пищевых жиров, молока и молочных продуктов.Учебник /
М. С. Касторин. В.А Кузмина, Ю.С Пучкова. - 4-е изд.доп. - М.: Издательско-
тергивая корпорация «Дашков и К», 2011. -328с.
. Куликова Н.Р
Товароведение и экспертиза чая и кофе: Учебное пособие / Н.Р Куликова. -
М.:Издательско- торговая корпорация. «Дашков и К», 2010. - 168с.
. Николаенко О.А.
Методы исследования рыбы и рыбных продуктов: учеб.пособие / О.А Николаенко Ю.В.
Шокина В.И Волченко. - ГИОРД, 2011. - 176с.
. Товароведение и
экспертиза продовольственных товаров: Лабораторный практикум /Под.ред. В.И.
Криштафович -2-е изд.-М. Издательско- торговая корпорация «Дашко и К», 2010 -
592с.
. Заикина В.И.
Экспертиза меда и способы обнаружения его фальсификации: Учебное пособие
/В.И.Заикина. -3-е изд; перераб и доп.- М.: издательско- торговая корпорация
«Дашков и К», 2010. - 168с.
. Кондрашова Е.
А. Товароведение продовольственных товаров: учеб. пособие для сред. проф.
образования / Е. А. Кондрашова, Н. В. Коник, Т. А. Пешкова. - М.: Альфа-М:
ИНФРА-М, 2007. - 415 с. Библиогр.: с. 413.
. Казанцева Н. С.
Товароведение продовольственных товаров: учебник [для студентов колледжей и
вузов экон. специальностей, уч-ся лицеев, училищ] / Н. С. Казанцева. - М.:
Дашков и К, 2007. - 399 с. Библиогр.: с. 393-394.
. Коник Н. В.
Товароведение продовольственных товаров: учеб. пособие для сред. проф.
образования / Н. В. Коник. - М.: Альфа-М: ИНФРА-М, 2009. - 415 с. - (ПРОФИль)
Библиогр.: с. 413.
. Действующие
ГОСТы на продовольственные товары
. Действующие
ГОСТы на непродовольственные товары